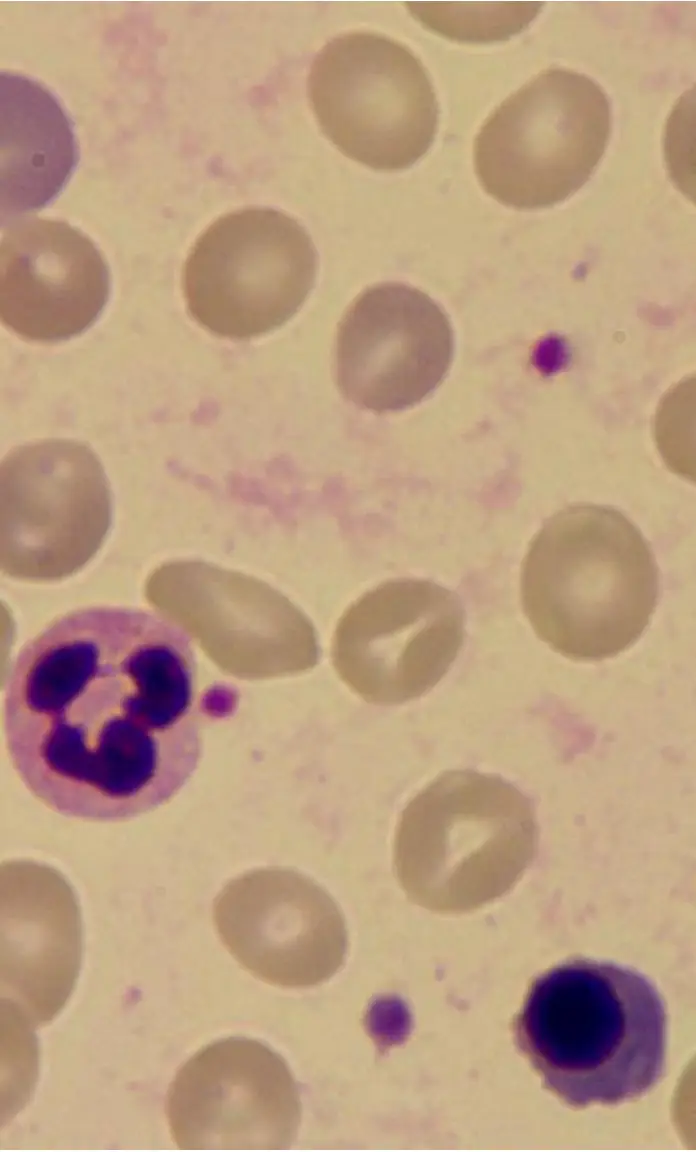
圖片描述
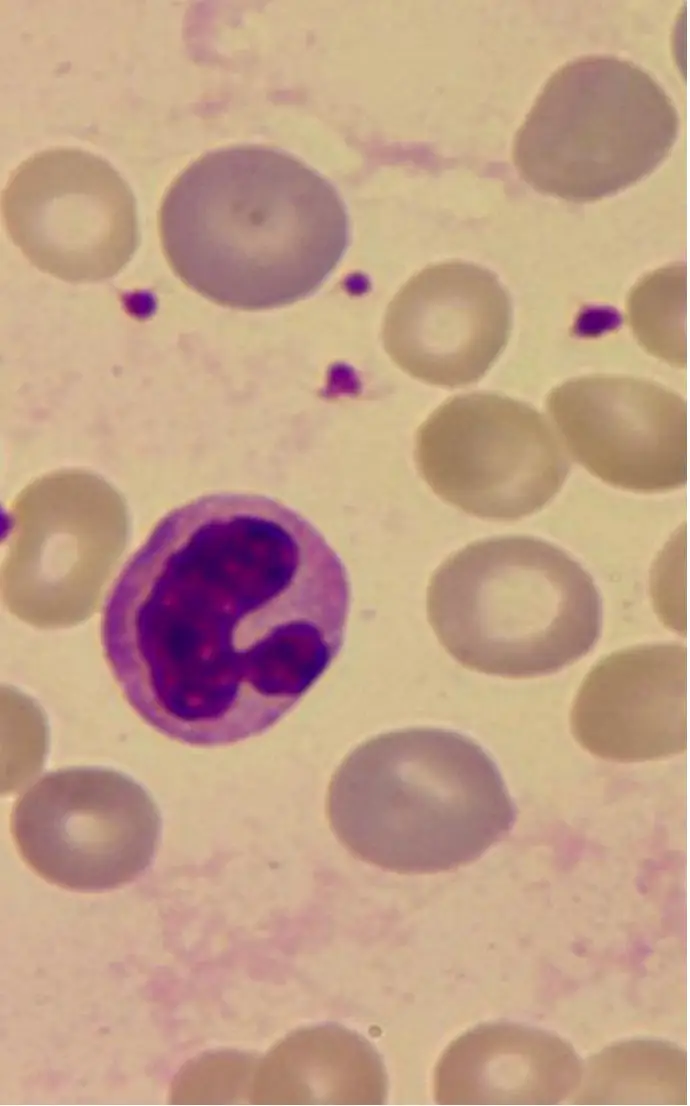
圖片描述

105年:內專
一位病人主訴呼吸急促,血液檢查顯示Hb 9.6 gm/dL,白血球及血小板數目正常,血液抹片如圖所示。此病人最可能的診斷為?

AAplastic anemia
BIron deficiency anemia
CHemolytic anemia
DVit B12 deficiency anemia
EThalassemia
詳細解析
本題觀念:
溶血性貧血(hemolytic anemia)是紅血球壽命縮短,導致血紅素降低的疾病。診斷需結合臨床表現(貧血症狀)、實驗室數據(血球計數、LDH、膽紅素、觸珠蛋白、網狀紅血球)及血液抹片形態學。本題病人有貧血合併白血球與血小板正常,血液抹片為關鍵診斷線索,需能辨識溶血特徵性細胞形態。
影像分析:
本題提供兩張血液抹片圖片:
圖片一(低至中倍視野):
- 紅血球(RBC)大小不均(anisocytosis),形狀各異(poikilocytosis)
- 可見碎裂紅血球(schistocytes/fragmented RBCs):呈三角形、頭盔狀(helmet cells)或不規則裂片
- 部分 RBC 呈橢圓形或異形,中央淡染區域變小(球形紅血球趨勢)
- 可見一顆嗜中性球(neutrophil),確認白血球形態正常
- 背景可見血小板散在分布,數目正常,與題目描述「血小板正常」吻合
圖片二(高倍視野):
- 中央可見一顆大型細胞,具有分葉、多形核或含有嗜紅性/深染顆粒的細胞質,形態符合吞噬細胞(macrophage)正在吞噬紅血球(erythrophagocytosis),或含 Heinz body 類包涵體的細胞
- 周圍可見 RBC 形態多樣,包括部分呈不規則收縮(spherocyte 特徵)
- 背景
...(解析預覽)...

升級 VIP 解鎖圖文解析